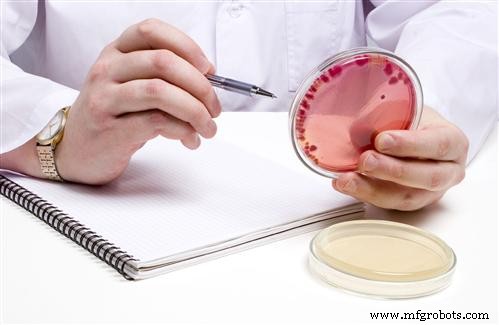
Ensuring Sanitary Practices in Pet Food Manufacturing: A Comprehensive Guide

Ensuring Sanitary Practices in Pet Food Manufacturing: A Comprehensive Guide
Pet food plant owners and operators are actively seeking innovative strategies to reconfigure existing facilities for pet‑food production. Recent salmonella recalls underscore the complex challenges inherent in manufacturing, packaging, and distribution. This article details how a leading pet‑food company transitioned from a grain‑processing mindset to a compliant, sanitary manufacturing environment.
Plant Culture
When the company sought to elevate food‑safety standards across several sites, it partnered with SSOE, a globally recognized engineering firm specializing in food, pharmaceutical, and consumer‑product manufacturing. An initial engineering assessment identified critical processes that could serve as contamination vectors. Leveraging SSOE’s cross‑industry sanitation expertise enabled successful, targeted enhancements.
SSOE also recognized that process redesign alone was insufficient; plant personnel’s understanding of sanitary practices required a cultural shift. Existing facilities had never processed human‑grade food, so FDA oversight was absent and a culture of clean manufacturing was non‑existent. Workers were unfamiliar with GMP principles, and management had not fully appreciated how plant layout and workplace culture must evolve to meet FDA and Good Manufacturing Practice (GMP) standards.
Key Contamination Pathways
Four primary contamination pathways must be scrutinized when converting a plant:
- The product flow from raw material to final packaging.
- The ambient environment within processing areas.
- Surrounding spaces such as hallways and packaging zones.
- Office, ancillary, and exterior areas.
Typical conversion targets include processing lines, floor surfaces, drains, waste systems, HVAC, dryers, raw‑ingredient handling, and packaging—essentially every system that interfaces with the product. To accelerate retrofits, SSOE often deploys a senior food‑processing engineer onsite to assess equipment, workflows, and personnel practices.
Surface Contact
All product‑contact surfaces warrant inspection for microbial proliferation. Moisture is a primary driver of bacterial growth; concrete, common in industrial settings, is porous and can retain water, creating ideal niches for pathogens. Mitigation strategies include applying antimicrobial sealants or coatings to concrete surfaces.
Product dust, or fines, accumulating at the base of equipment can also serve as an overlooked contamination source. Proper collection and routing of fines—separating them from finished products—are essential to prevent cross‑contamination.
Air Flow
Plants adjacent to agricultural zones often experience airborne contaminants such as dust, pollen, and pesticides. Implementing a positive‑pressure system—creating a pressure differential that keeps contaminants out of sanitary areas—is a proven strategy in food manufacturing, though less common in pet‑food facilities. Designing effective positive‑pressure zones may necessitate additional fans, ductwork, and filtration.
Water‑Related Issues
Water is indispensable in manufacturing, yet it can also be a conduit for microbes if not properly managed. Surfaces that retain moisture—walls, floors, ceilings—can foster bacterial growth. While sealing surfaces can reduce risk, a more robust approach is to limit water usage. Facilities that rely on water for cleaning should consider alternatives such as vacuum systems or pressurized CO₂ cleaning.
Although grain‑processing plants can be repurposed for sanitary pet‑food production, careful assessment of contamination pathways and process controls is mandatory. Recent salmonella outbreaks illustrate that pet‑food contamination can pose serious public‑health risks, making rigorous sanitation essential for all manufacturers.
Central to successful conversion is partnering with an engineering consultant experienced in food and product safety. Such experts bring cross‑industry insights—from food and beverage to pharmaceuticals—to the redesign process. Equally important is fostering a cultural shift among management and staff; the consultant’s guidance can accelerate this transition, ensuring that pet‑food manufacturers can confidently market their products as safe, healthy, and trustworthy.
About the author:
David S. Mast, PE, senior project manager at SSOE Group, is an international engineering, procurement, and construction management firm. With nearly 20 years of experience, David specializes in consumer‑product and pet‑food projects, as well as offshore engineering integration. He can be reached at 419‑222‑7794 or DMast@ssoe.com.

Figure 1. Air Flow

Figure 2. Concrete Surfaces

Figure 3. Crusty Drain
Figure 4. Examine Microbial Growth
Equipment Maintenance and Repair
- Pet Food Production: From Ingredients to Regulation – A Complete Guide
- Predictive Plant Maintenance for Food Processing: Boost Safety, Reliability, and Efficiency
- Industrial IoT Forecast 2018: How Smart Plants Are Transforming Manufacturing
- Synthetic PAO Gear Oil Extends Food-Plant Worm Gearbox Life by 350%
- Eco‑Friendly Paint Clean‑Up: Proven Practices for Maintenance Professionals
- Hill’s Pet Nutrition Upgrades Control System to Eliminate I/O Failures and Boost Productivity
- Preventing Tunnel Vision: A Proactive Approach to Plant Safety and Reliability
- Washdown Pump Motors: Ensuring Reliable, Sanitary Operation in Food Processing
- Smart Plant Communicator: Arduino MKR IoT Bundle for Automated Gardening
- Top Excavator Safety Practices: Protect Your Crew and Equipment